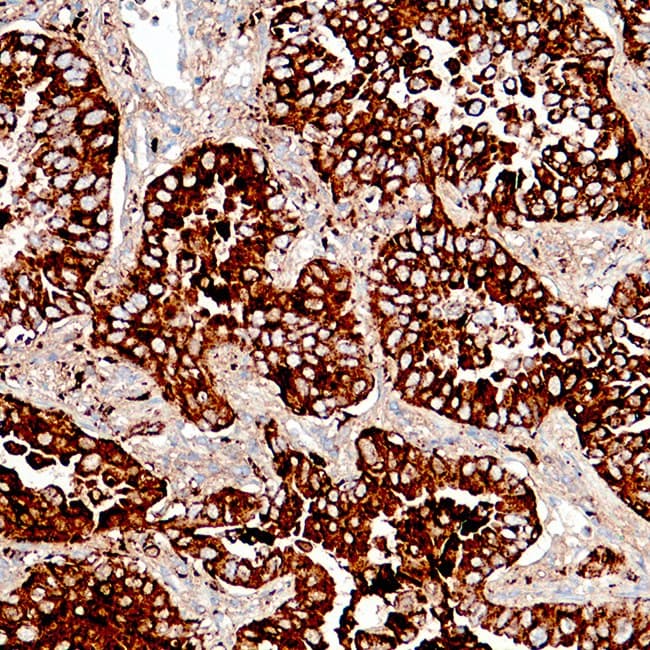
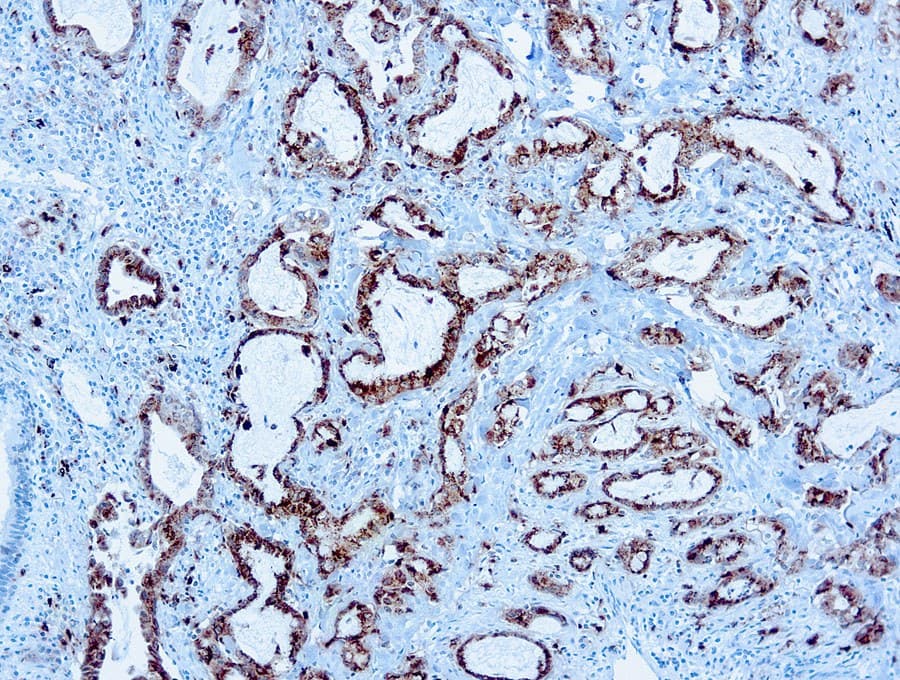

En patología pulmonar, la Napsina A muestra un patrón de expresión relativamente restringido, principalmente en los neumocitos tipo II, lo que respalda su uso como marcador inmunohistoquímico en los enfoques de clasificación de tumores. Los estudios publicados y las guías de práctica diagnóstica describen su utilidad en la evaluación del adenocarcinoma de pulmón, especialmente cuando se utiliza en combinación con otros marcadores como el TTF-1 para apoyar la asignación del linaje en el carcinoma de pulmón no microcítico. Su interpretación se realiza típicamente dentro de paneles de anticuerpos y en correlación con la histomorfología, dado que ningún marcador individual es totalmente específico para el origen o subtipo tumoral.
Significado Biológico de la Napsina A
- Proteasa aspártica: Implicada en el procesamiento de proteínas asociadas al surfactante en los neumocitos alveolares tipo II, según se describe en estudios experimentales y patológicos.
- Expresión fisiológica: Localizada principalmente en el epitelio alveolar pulmonar, con expresión reportada en el epitelio tubular proximal renal en estudios seleccionados.
- Expresión restringida a tejidos: Respalda su uso como marcador inmunohistoquímico asociado al linaje en la evaluación de tumores epiteliales.
Utilidad Diagnóstica de la Napsina A en Patología Pulmonar
- Se utiliza en paneles inmunohistoquímicos que apoyan la clasificación del adenocarcinoma primario de pulmón.
- Los estudios reportan una sensibilidad y especificidad variables pero generalmente útiles cuando se interpretan junto con la morfología y el contexto clínico.
- Comúnmente evaluada junto con TTF-1 para apoyar la asignación del linaje tumoral en el carcinoma de pulmón no microcítico.
- Utilizada en el diagnóstico diferencial del adenocarcinoma de pulmón frente al carcinoma de células escamosas, tumores neuroendocrinos y adenocarcinomas metastásicos.
- La interpretación requiere correlación con la morfología y marcadores adicionales debido a la expresión reportada en tumores no pulmonares seleccionados, incluyendo neoplasias epiteliales renales.
Características Clave de los Anticuerpos Anti-Napsina A CE/IVD
- Destinados a la detección por IHQ de Napsina A en tejidos fijados en formalina e incluidos en parafina en flujos de trabajo validados.
- Detecta una tinción granular citoplasmática asociada con la diferenciación de células alveolares tipo II.
- Utilizados como parte de paneles diagnósticos para la clasificación del adenocarcinoma de pulmón y el diagnóstico diferencial de tumores pulmonares frente a metastásicos.
- La clasificación CE/IVD indica la conformidad con los requisitos reglamentarios aplicables para el uso diagnóstico in vitro en laboratorios clínicos.